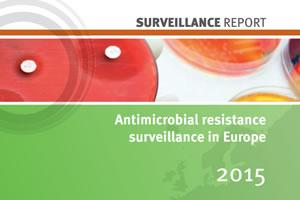
resistencia antibióticos

La resistencia de bacterias patógenas a los antibióticos sigue creciendo en Europa. Este serio problema de salud pública, asociado a un uso imprudente de los antibióticos y a deficiencias en las estrategias de prevención y control de las infecciones, es más agudo en el sur y el este de la UE. Especialmente preocupa la multiresistencia de las bacterias a diversos agentes antibióticos, que limita severamente las alternativas de tratamiento de las infecciones.